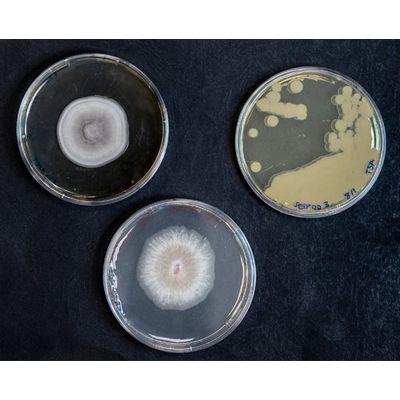

Seipasa, s.a products
Natural Technology
Natural Technology for Seipasa means providing effective solutions for agriculture based on innovation and research applied to active substances of botanical and microbiological origin. On this basis the company has developed its Natural Technology® model, which it applies to the formulation, development and production of bioinsecticides, biofungicides, biostimulants and fertilizers.
Biopesticides
Seipasa - Bioinsecticides
Seipasa’s bioinsecticides are highly technical phytosanitary products that are developed from substances of botanical and microbiological origin. The decreasing range of active substances available in the market and the onset of resistances to traditional chemical solutions, means that Seipasa`s natural technology provides the alternative and/or complement that farmers need. It is an effective alternative to conventional synthetic insecticides.
Seipasa - Biofungicides
Seipasa’s biofungicides are phytosanitary products that are designed based on substances of botanical and microbiological origin. They are highly technical solutions that Seipasa has developed from its extensive experience in R+D+I applied to agriculture.